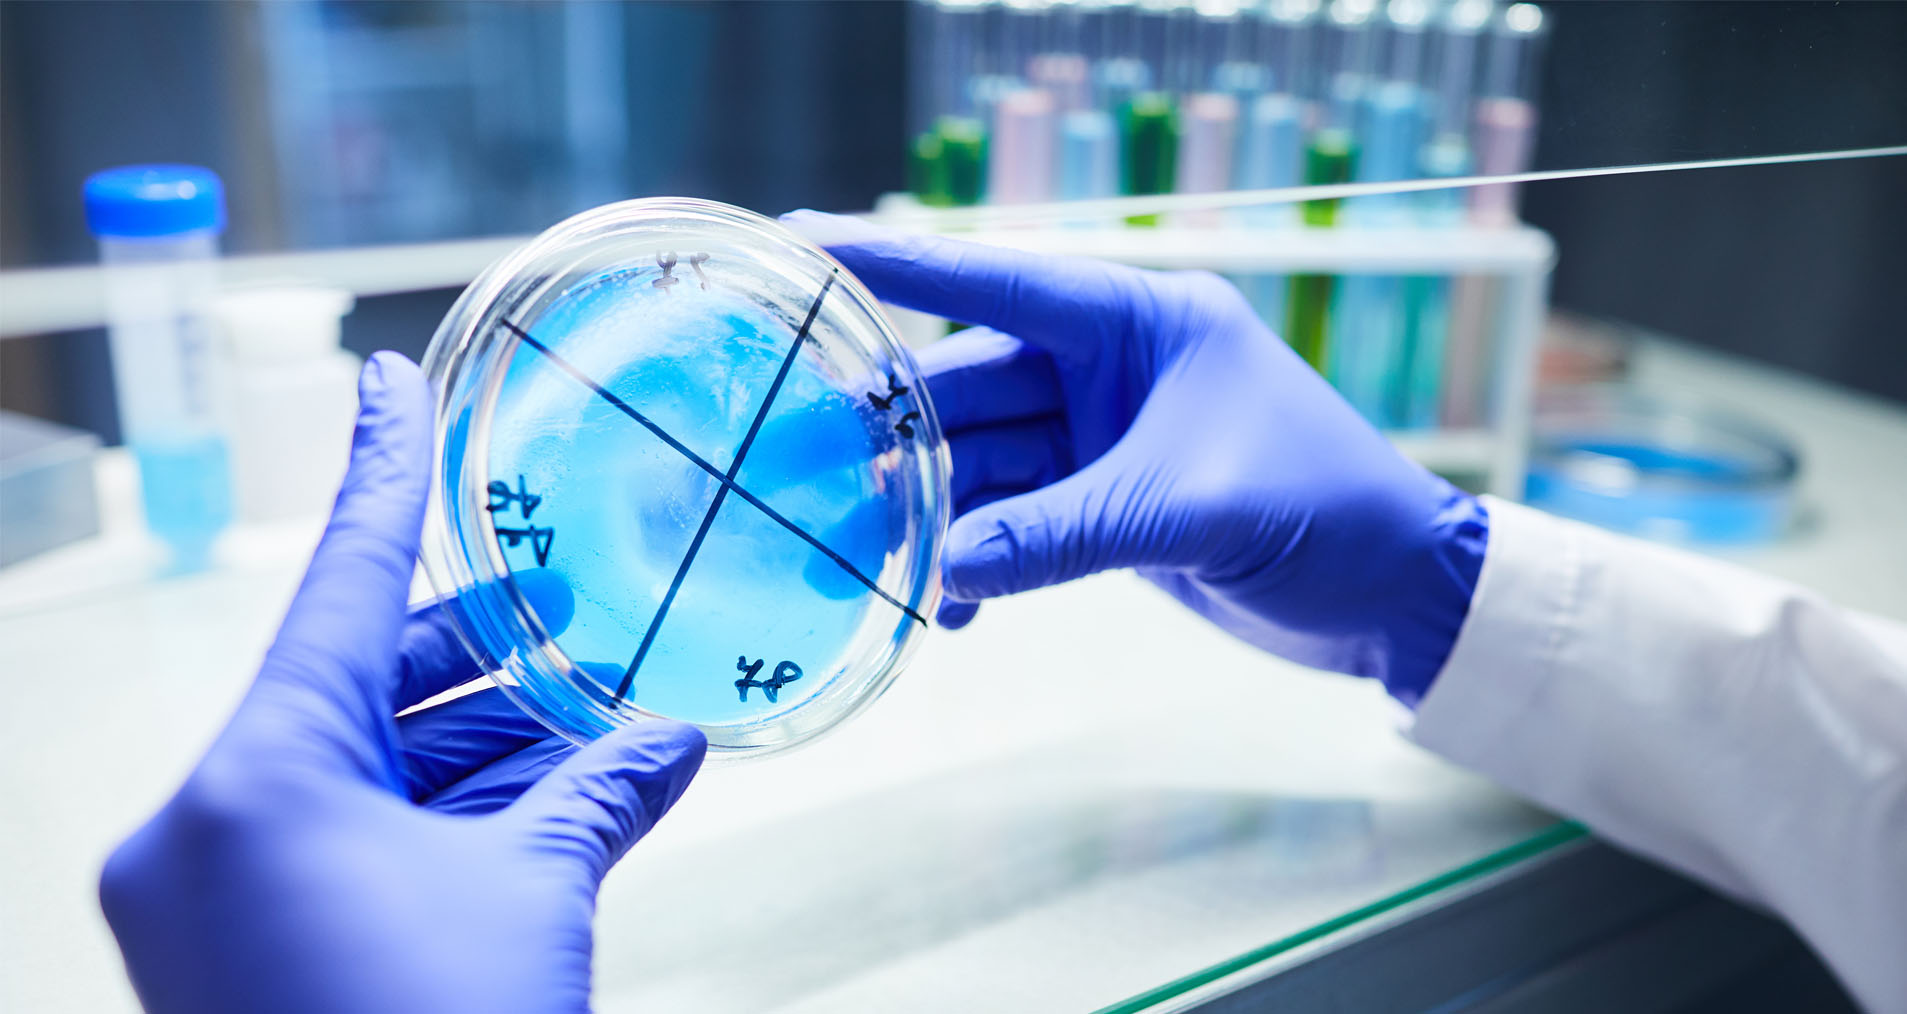

We have a strong pipeline of plant-based functional ingredients that can be used in a wide array of applications including food, beverages and supplements.
Our ingredients are plant based and constitute a complex mixture of compounds with versatile functional characteristics such as antidiabetic, antioxidants, antibiotic, antiviral, anticancer, antiparasitic, antifungal, hypoglycaemic, antihypertensive, and insecticidal properties.
We are also targeting pockets of growth such as energy boosting, digestion and brain health related functional ingredients among others.
As an example, our proprietary [Functional Ingredient Name] leverages plant based nanoparticles to modulate food bioavailability.